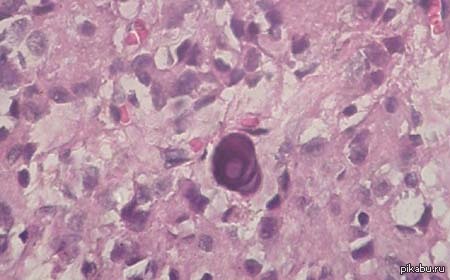

Глаз Гора и эпифиз
Для того чтобы понять происхождение «Всевидящего ока» (глаз Гора) нужно вспомнить древнеегипетскую мифологию.
Самое большое могущество приписывалось Сету – яростному богу разрушения и войны; его брату Осирису – старейшему египетскому богу; жене Осириса Исиде – богине природы, которая являлась олицетворением истинной женщины.
Сет был ненавистником своего брата, так как не хотел разделять с ним владение миром. Он коварно убивает Осириса и единолично владеет землей и небом. Беременная Исиде не может противостоять Сету, но возрождает мужа. Разгневанный бог ярости и разрушения повторно убивает брата с последующим расчленением его тела. Отдельные фрагменты он спрятал в разных частях Египта. Исида не смогла их найти, чтобы воскресить мужа вновь – он остался в Египте и стал его покровителем.
Тем временем Исида родила сына Гора и отправила его на землю, чтобы уберечь его от воинственного Сета. Повзрослевший Гор узнает о своем происхождении и убийстве отца. Он жаждет мести и власти. Между богами начинается война. На стороне Гора были: Исида, брат Анубис (покровительствовавший загробному миру и кладбищам) и Тот (бог знаний и мудрости). На войне Гор теряет левый глаз. Но Хатхор (богиня Неба) глаз возродила. Гор с помощью этого глаза смог воскресить отца. Проглотив его, Осирис восстановил свое тело, срастив все его фрагменты.
Глаз Гора становится символом защиты и исцеления. Рассчитывая на воскрешение после смерти, египтяне стали наносить на мумии его изображение возле отверстия, из которого вынимались внутренности умершего. Позже левый глаз символизировал Луну, а правый – Солнце. Каждый месяц в храмах страны проводился обряд восстановления, в соответствии с циклами Луны. Этот могущественный амулет носили фараоны и простые египтяне.
Они до сих пор используют его изображение как сильнейший амулет.
Так же очевидное сходство между глазом Гора и человеческим мозгом в надрезе, а сам глаз является эпифизом. Так же известным как "третий глаз".
В ряде теорий, предложенных разными исследователями, делается предположение, что эндогенный ДМТ, производимый человеческим мозгом в определённых психологических и нейрологических состояниях, используется организмом для индуцирования визуальных эффектов в процессе естественных сновидений, переживаний клинической смерти и преагональных состояний мозга, а также других переживаний мистического толка. Биохимический механизм этого явления был предложен исследователем JC Callaway в работе 1988 года, где делалось предположение, что ДМТ может быть связан с феноменом сновидений, и другими естественными состояниями мозга, где механизмом является повышение уровня эндогенного ДМТ в головном мозге человека.
В исследованиях Рика Страссмана в 1990-х годах было высказано предположение, что мозг человека производит выброс большого количества ДМТ из эпифиза в момент, предшествующий смерти, или при переживании околосмертного состояния. Этим объясняются интенсивные визуальные эффекты, сообщаемые пережившими клиническую смерть или околосмертное состояние людьми. В 1950-х годах была популярна теория о том, что эндогенная выработка психоактивных агентов объясняет симптоматику испытывающих галлюцинации пациентов с некоторыми психическими заболеваниями. В частности, таким образом пытались найти объяснение шизофрении. Однако данная теория не могла объяснить присутствие эндогенного ДМТ в нормальных здоровых людях, а также у лабораторных мышей и других животных. В свете этого предположение о функции эндогенного ДМТ в качестве агента, вызывающего визуальные эффекты естественных сновидений, выглядит более основательным.
Однако точное доказательство этого предположения невозможно по этическим соображениям — биологические образцы для исследования должны быть получены из живого мозга человека.
Теренс МакКенна, автор ряда книг, где упоминается тема ДМТ, описывал свой опыт употребления, в котором произошла встреча с существами, названными им «Самотрансформирующиеся машины-эльфы» (англ. Self-Transforming Machine Elves). МакКенна приписывает ДМТ роль инструмента, который может быть использован для связи с существами из других миров. Подобные отчеты также дают другие пользователи, испытавшие DMT-трипы. Также часто сообщается о встречах с разумными существами, которые пытаются выяснить информацию о нашей реальности.
«ДМТ: Молекула Духа» (англ. DMT: The Spirit Molecule) — одна из самых известных книг о ДМТ, написанная Риком Страссманом, ученым-исследователем в области медицины.
Страссман выдвигает предположение, что эпифиз вырабатывает ДМТ в естественном процессе, ввиду того, что все необходимые компоненты для этого процесса обнаруживаются именно там. Однако никто ещё не пытался обнаружить ДМТ в эпифизе напрямую.